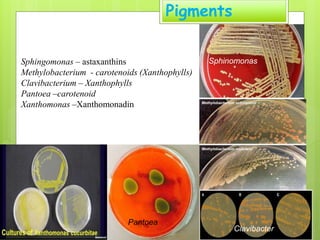
Pigments
Sphinomonas
Pantoea
Clavibacter
Sphingomonas – astaxanthins
Methylobacterium - carotenoids (Xanthophylls)
Clavibacterium – Xanthophylls
Pantoea –carotenoid
Xanthomonas –Xanthomonadin

The document discusses insights into the phyllosphere, the surface of aerial plant parts, and its microbial community dynamics, highlighting types of microbes and their survival strategies against environmental stresses. It outlines the history of phyllosphere research, the ecological factors influencing microbial diversity, and the functional roles of phyllospheric microflora, such as promoting plant growth and remediating pollutants. Additionally, it emphasizes the importance of understanding these microorganisms for biotechnological applications in agriculture and environmental health.